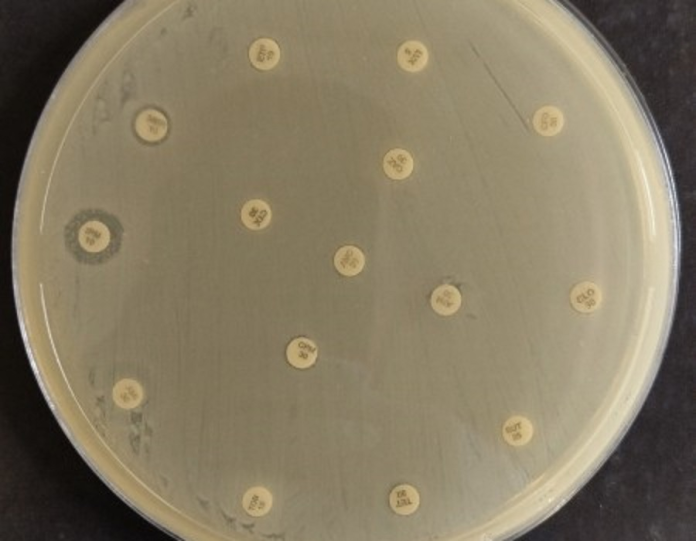

Pesquisa mostra que bactéria Klebsiella pneumoniae é encontrada em ambiente hospitalar e não existe antibióticos capazes de eliminá-la
Uma bactéria altamente resistente — que não responde a nenhum antibiótico — e com capacidade de se disseminar facilmente pelo mundo. A descoberta de uma cepa da bactéria Klebsiella pneumoniae é o resultado de uma pesquisa feita pelo professor do Instituto de Ciências Biomédicas da Universidade de São Paulo (ICB-USP) Nilton Lincopan e apoiada pela Fundação de Amparo à Pesquisa do Estado de São Paulo (Fapesp).
A nova cepa foi encontrada em uma mulher de 86 anos com infecção urinária num hospital da região Nordeste, em 2022. A paciente morreu 24 horas depois de dar entrada na unidade de saúde.
O genoma da bactéria foi sequenciado por um grupo de pesquisadores, que o comparou com um banco de dados de 408 outras sequências parecidas. O resultado, segundo o grupo, é alarmante e há risco de que a bactéria se espalhe pelo mundo.
O coordenador da pesquisa explica os riscos.
“Com relação ao perigo que essa bactéria oferece, poderia ter um ponto de vista biológico e outro clínico. Biologicamente o problema seria disseminar rapidamente podendo ser endêmica em alguns hospitais. Agora clinicamente falando, o problema poderia ser a produção de infecções em pacientes com patologias infecciosas com redução do quadro imunológico ou como consequência de algum procedimento invasivo como por exemplo, a ventilação mecânica.”
Bactéria circula em hospitais
O médico infectologista Marcelo Daher conta que essa bactéria é uma grande preocupação dentro dos hospitais e que ela já circula, inclusive, entre pacientes que não estiveram internados.
“Representa um problema sério para o meio científico pela alta resistência que ela apresenta aos antibióticos, então nós temos pouca opção de tratamento. Ela representa um grave problema para os pacientes mais graves e internados. Já para os pacientes hígidos, ou sem nenhum problema de saúde, ela raramente apresenta um problema sério, já que não tem capacidade de causar uma doença mais séria nessas pessoas.”
Cuidado com antibióticos
Os pesquisadores envolvidos no trabalho chamam atenção para a importância do monitoramento permanente das cepas bacterianas encontradas nos hospitais. Outro alerta é com relação à prescrição de antibióticos, que deve ser feita de forma consciente.
Para os pacientes, a mensagem é que, quando tiverem antibióticos prescritos para si, façam o tratamento até o fim, mesmo que se sintam bem após dois ou três dias. A prática também evita o surgimento de cepas resistentes.
De forma científica, o infectologista Marcelo Daher explica que a Klebsiella “ensina” as outras bactérias a “fugir” dos antibióticos e garantir resistência aos medicamentos.
O advento dessas bactérias multirresistentes vem pelo uso indiscriminado e até mesmo desnecessário dos antibióticos.
“A racionalização, o uso correto dos antibióticos, vai ajudar a diminuir o risco ou a chance dessas bactérias aumentarem e continuarem a ser um problema nos ambientes hospitalares.”
Uma pesquisa divulgada pela revista científica The Lancet, no mês passado, mostra que mais de 39 milhões de pessoas no mundo podem morrer em decorrência de infecções causadas por bactérias resistentes aos antibióticos nos próximos 25 anos.
Segundo o levantamento, entre 1990 a 2021, a resistência aos antibióticos foi responsável pela morte de mais de um milhão de pessoas em todo o mundo — a maior parte dessas mortes foi causada pelo Staphylococcus aureus.
Notificação
O médico e pesquisador explica que toda vez que esses microrganismos multirresistentes são encontrados, a primeira providência é notificar a vigilância epidemiológica local. Além disso, é fundamental isolar o paciente e aumentar os cuidados com a equipe para evitar a contaminação de outros pacientes.
Fonte: Brasil 61
Foto: Rubens Renato Carmo/USP